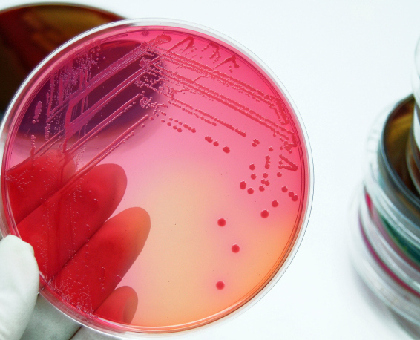
La coproculture ou analyse des selles

Analyses et examens médicaux
L'imagerie sectionnelle 3D en chirurgie dentaire
La radiographie est indispensable dans le domaine de la médecine dentaire. Elle permet d'examiner avec précision la structure dentaire et de poser des diagnostics justes. Elle est aussi utile si une intervention chirurgicale est envisagée. Lire la suite
Les échographies prénatales : des examens essentiels
Réalisées depuis les années 1970, les échographies prénatales sont devenues des examens très importants dans le suivi du développement fœtal, non seulement pour que les parents découvrent leur enfant, mais surtout pour visualiser les éventuelles anomalies et malformations. Lire la suite
La cœlioscopie : une chirurgie très peu invasive
La coelioscopie a été une véritable révolution pour la chirurgie car elle présente de nombreux avantages, notamment en post-opératoire. Mais comment se passe exactement une opération sous cœlioscopie ? Cette méthode peut-elle être utilisée dans toutes les situations ? Lire la suite
Le spermogramme : le meilleur diagnostic de l’infertilité masculine
Le spermogramme est un examen simple à effectuer en pratique, mais pas forcément facile à envisager pour un homme. Pourtant, c’est la meilleure façon de détecter une infertilité masculine. Tout comprendre sur cet examen : ce qu’on analyse, comment cela se passe en pratique… Lire la suite
Dépistage du cancer du sein : comment réaliser les gestes d’autopalpation
Il est question d’élargir le dépistage organisé du cancer du sein, prévu actuellement tous les 2 ans pour les femmes âgées de 50 à 74 ans, aux femmes à risques aggravés (facteurs génétiques, familiaux…). Mais le dépistage passe aussi par une autopalpation que vous pouvez faire régulièrement à la maison : apprenez, avec nous, les gestes de... Lire la suite
Cholestérol, triglycérides, HDL, LDL… Savoir interpréter ma prise de sang
Je suis sous contraceptif oral et mon médecin m’a prescrit une prise de sang pour vérifier mon taux de cholestérol : sur mon ordonnance, je lis cholestérol total, HDL, LDL, triglycérides… à quoi cela correspond-il ? Lire la suite
L’amniocentèse, un examen pour détecter les anomalies du foetus
Votre médecin vous a prescrit une amniocentèse parce qu’il a un doute après une échographie ou une prise de sang ? Ne vous inquiétez pas, dans la majeure partie des cas, elle permettra de vous rassurer et les médecins seront ainsi absolument certains que tout va bien. Lire la suite
Bilan hépatique : une prise de sang pour évaluer le fonctionnement de mon foie
Mon médecin m’a dit qu’il me faisait faire une prise de sang pour un bilan hépatique, mais je ne comprends pas bien sa prescription : gamma GT, transaminases, phosphatases alcalines… A quoi cela correspond-il ? Lire la suite
Examens de la thyroïde : échographie, scintigraphie et biopsie
Dans certains cas, la thyroïde augmente en volume pour former des goitres qui peuvent contenir des nodules. Différents examens permettent de déterminer le caractère bénin ou malin de ces nodules. Vous devez passer l'un de ces examens et vous appréhendez ? On vous en dit plus sur la scintigraphie, l'echographie et la biopsie. Lire la suite
Thyroïde : que dose-t-on dans le bilan sanguin ?
En cas de doute dans le fonctionnement de votre thyroïde, le médecin vous prescrira une prise de sang pour analyser les différentes hormones qui agissent sur la thyroïde ou qui sont sécrétées par celle-ci : quelques explications pour vous aider à décrypter votre bilan sanguin. Lire la suite
Les nouveaux neurones d'un cerveau adulte peuvent être stimulés par la lumière
Des chercheurs de l'Intitut Pasteur et du CNRS ont mis en évidence que les nouveaux neurones naissant dans un cerveau adulte peuvent être stimulés par la lumière. Cette découverte pourrait ouvrir la voie à une nouvelle démarche thérapeutique pour lutter contre les maladies neurodégénératives comme la maladie d'Alzheimer. Lire la suite